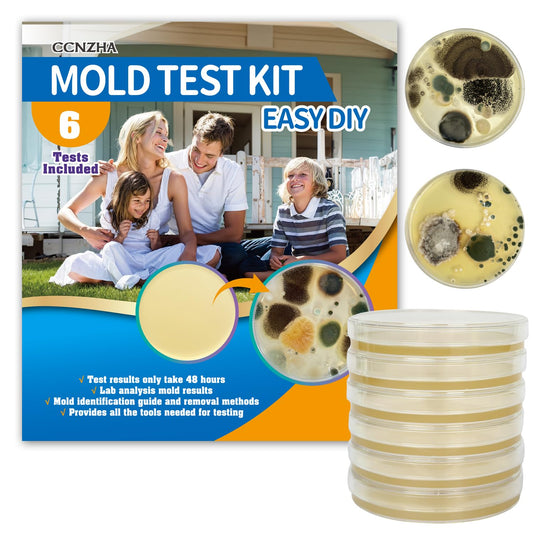
Mold Test Kit for Home -DIY Mold Testing Kit with 6 Individual Tests-Black Mold Detector-Indoor Air Quality Tester-Mold Identification Guide-Free Lab Analysis-Fast and Reliable Mold Detector at Home

-
MOJOCO Portable Clothes Dryer - Mini/Compact Dryer for Apartment, RV, Travel - Small Quiet Fast-Drying Machine with Adjustable Timer & Hassle-Free Setup
Regular price $199.99Sale price $199.99 Regular priceUnit price per$399.9950% -
MokerLink 4 Port PoE Switch, 1 Gigabit Uplink, 1 SFP, IEEE802.3af/at 75W, PoE Watchdog AI Detection, QoS, Fanless Metal Plug & Play Ethernet Switch
Regular price $53.99Sale price $53.99 Regular priceUnit price per$107.9950% -
MokerLink 4 Port PoE Switch, 1 Gigabit Uplink, 1 SFP, IEEE802.3af/at 75W, PoE Watchdog AI Detection, QoS, Fanless Metal Plug & Play Ethernet Switch
Regular price $53.99Sale price $53.99 Regular priceUnit price per$107.9950% -
MoKo Lightning Female to USB C Male Adapter for iPhone 17 Air 16 15 Pro Max Plus, Galaxy, iPad - Not for Earphone/USB Stick/iPencil, 2 Pack USB-C to Lightning Adapter ONLY for Charging/Data Transfer
Regular price $11.99Sale price $11.99 Regular priceUnit price per$23.9950% -
MoKo Secure Travel Money Belt, Undercover Hidden RFID Blocking Travel Wallet, Anti-Theft Passport Wallets for Men Women, Black
Regular price $19.99Sale price $19.99 Regular priceUnit price per$39.9950% -
MoKo Yoga Towel, Non Slip Hot Yoga Mat Yoga Blanket Printing Pattern Quick Dry with Corner Pocket for Bikram, Pilates, Gym Workout, Outdoor Picnic, Lotus
Regular price $33.99Sale price $33.99 Regular priceUnit price per$67.9950% -
Mokof 4-Pack Wood Wall Planters for Fake Plants and Dried Flowers Stems, 12" Slim Modern Wooden Vases Wall Decor for Living Room, Bedroom, Bathroom, Apartment
Regular price $35.99Sale price $35.99 Regular priceUnit price per$71.9950% -
Moku Home Replacement Scrubber Refill for Extendable Tub Tile Shower Brush for Cleaning Non-Scratch (2X Scrubber Sponge Red)
Regular price $17.99Sale price $17.99 Regular priceUnit price per$35.9950% -
Moku Plant-Based Mushroom Jerky, Korean BBQ (3 Pack), Gluten Free, Soy-Free, Non-Gmo Vegan Snacks, No Artificial Sweetener Vegan Food, Healthy Snacks, 2.0 Oz Ea
Regular price $39.99Sale price $39.99 Regular priceUnit price per$79.9950% -
MOLAER Rechargeable Flashlights 2200 High Lumens, Super Bright LED Flashlight with Zoomable, 6 Modes, IPX6 Waterproof, Powerful Tactical Handheld Flash Light for Camping, Hiking, Emergencies
Regular price $53.99Sale price $53.99 Regular priceUnit price per$107.9950% -
Molasus Women's Soft Cotton Underwear Briefs High Waisted Postpartum Panties Ladies Full Coverage Plus Size Underpants Black, Large
Regular price $51.99Sale price $51.99 Regular priceUnit price per$103.9950% -
Mold Armor Do It Yourself Mold Test Kit
Regular price $19.99Sale price $19.99 Regular priceUnit price per$39.9950% -
Mold Test Kit for Home - 12 Simple Detection Tests,Test HVAC System,Home Surfaces,& Indoor Air Quality Testing Kits,DIY Mold Detector at Home,Includes Detailed Mold Identification Guide,air Tester
Regular price $52.99Sale price $52.99 Regular priceUnit price per$104.9949% -
Mold Test Kit for Home - 12 Simple Detection Tests,Test HVAC System,Home Surfaces,& Indoor Air Quality Testing Kits,DIY Mold Detector at Home,Includes Detailed Mold Identification Guide,air Tester
Regular price $52.99Sale price $52.99 Regular priceUnit price per$104.9949% -
Mold Test Kit for Home -DIY Mold Testing Kit with 6 Individual Tests-Black Mold Detector-Indoor Air Quality Tester-Mold Identification Guide-Free Lab Analysis-Fast and Reliable Mold Detector at Home
Regular price $26.99Sale price $26.99 Regular priceUnit price per$53.9950% -
Mold Test Kit for Home Within 6 Individual Tests,DIY Detector at Home,Surface Mold,HVAC,Indoor Air Quality Testing Kits,Black Mold Testing,Includes Detailed Mold Identification Guide and Free Lab
Regular price $29.99Sale price $29.99 Regular priceUnit price per$59.9950% -
Mole Repellent Solar Powered 4 Pack,Snake Vole Repellent Outdoor, Gopher Repeller Ultrasonic Solar Powered for Lawn Garden Waterproof, Sonic Mole Spikes,Get Rid of Moles Groundhog Chipmunk Repellent
Regular price $48.99Sale price $48.99 Regular priceUnit price per$97.9950% -
Mole Repellent Solar Powered Gopher Repellent Ultrasonic Solar Powered Sonic Mole Deterrent Stakes, Snake Groundhog Repellent for Yard, Garden, Lawn (4 Pack)
Regular price $71.99Sale price $71.99 Regular priceUnit price per$143.9950% -
MOLICAR Gun Safe, Biometric Gun Safes for Handgun with LCD of Temp Humidity Battery, USB-C Port, Fingerprint Quick Access Pistol Safe for Home Bedside Nightstand Car
Regular price $159.99Sale price $159.99 Regular priceUnit price per$319.9950% -
Molithe 100% Wool Blanket, 62" x 86", Warm, Thick, Washable, Military Wool Blanket, Great for Camping, Outdoors, Sporting Events, Survival Kits,Carbon Black
Regular price $89.99Sale price $89.99 Regular priceUnit price per$179.9950%